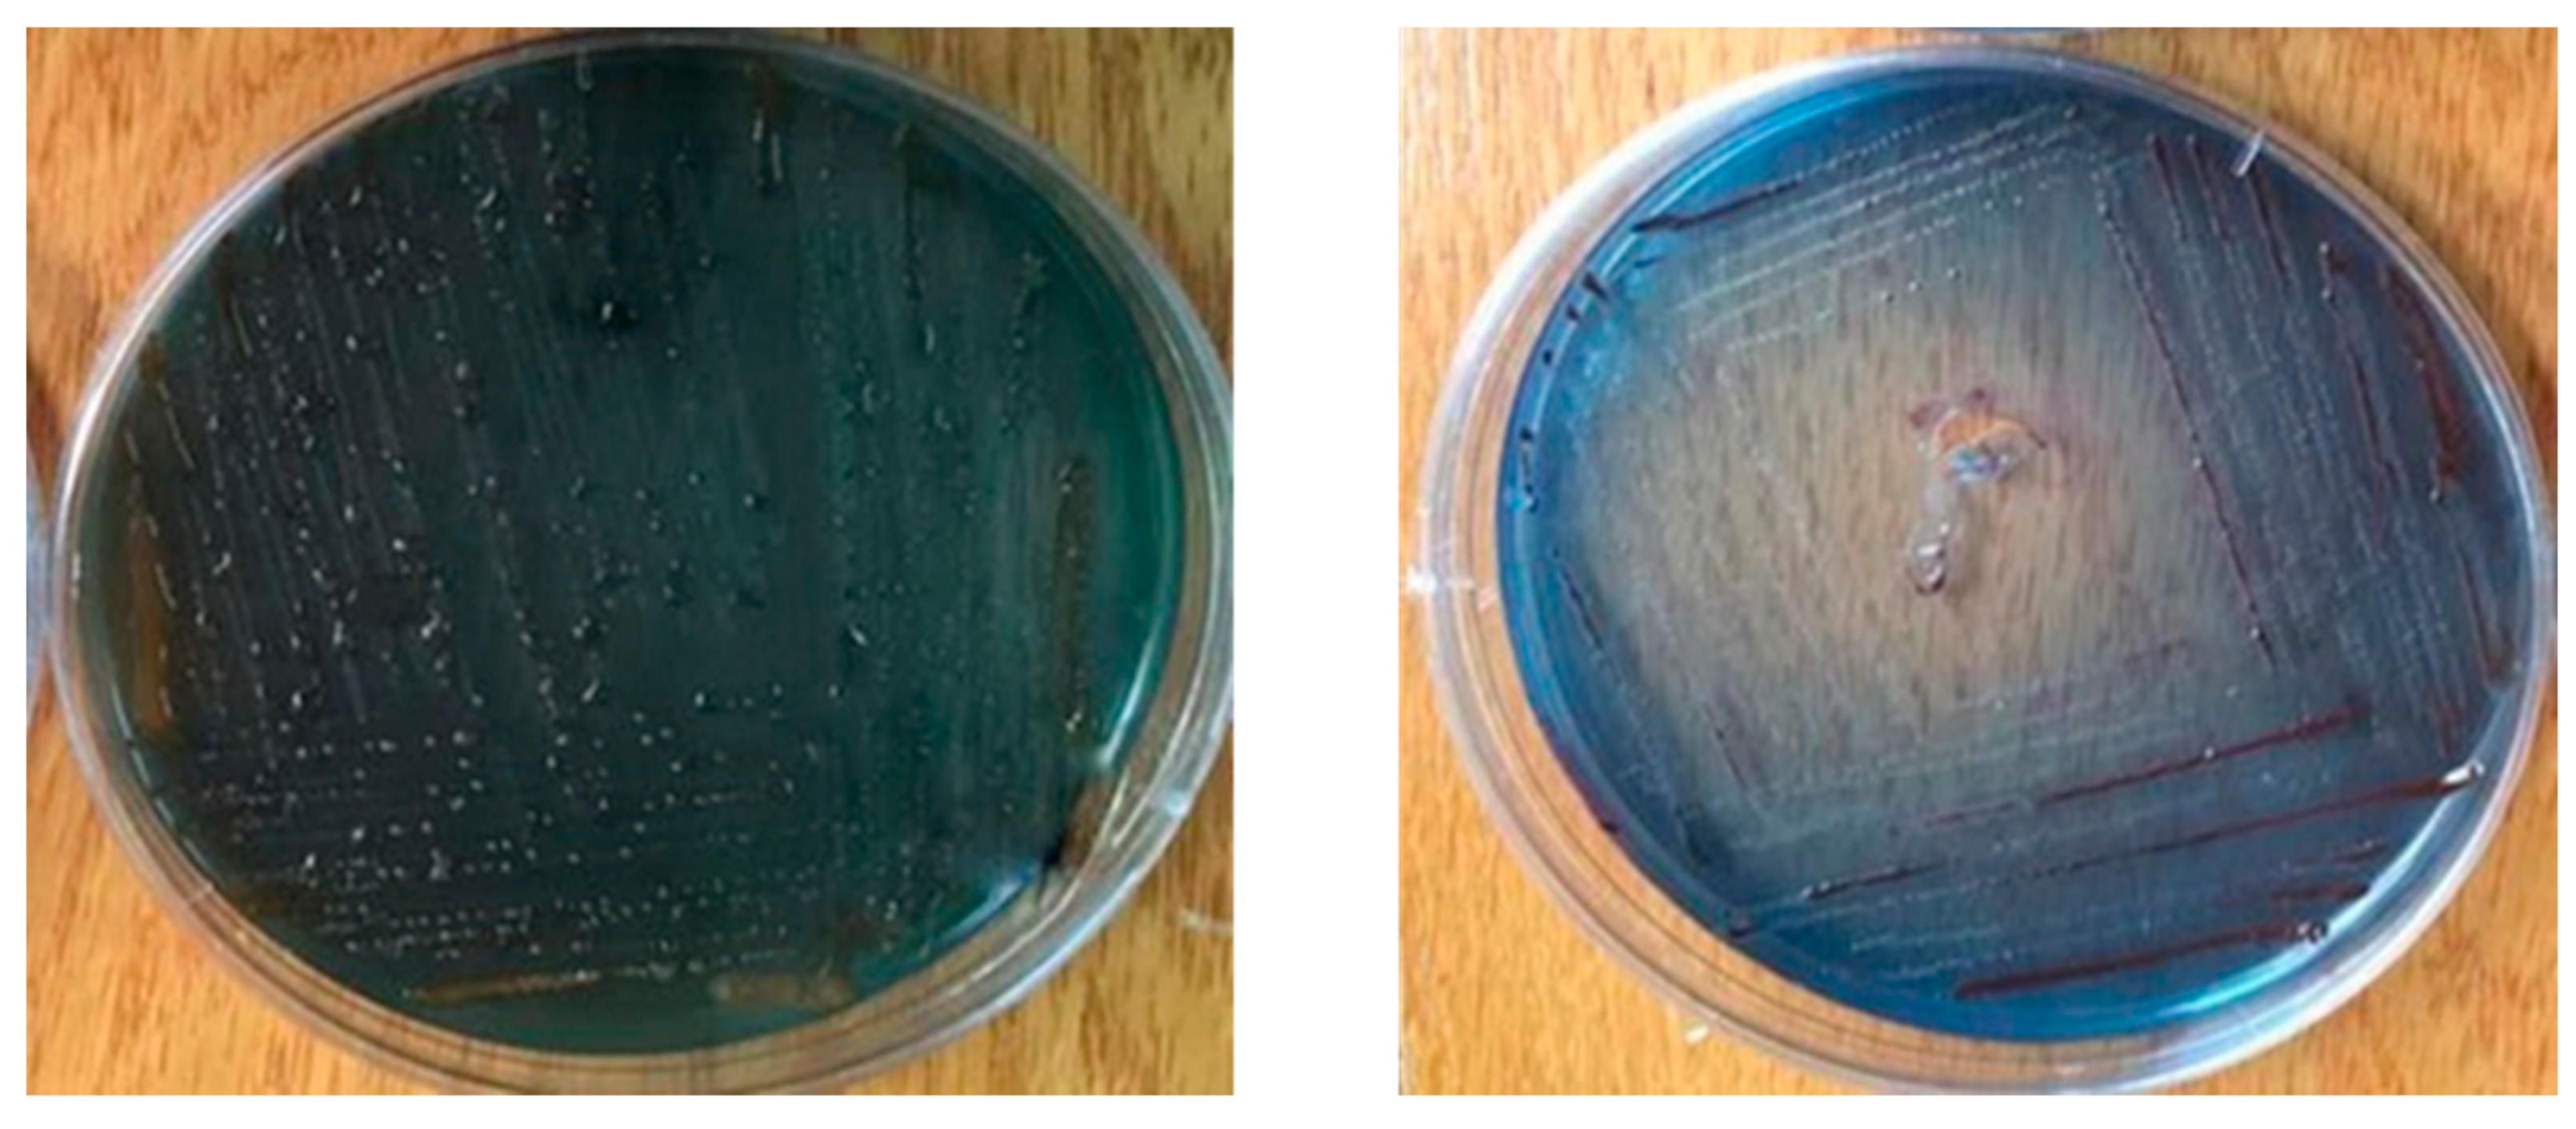
Biology 10 00999 g004
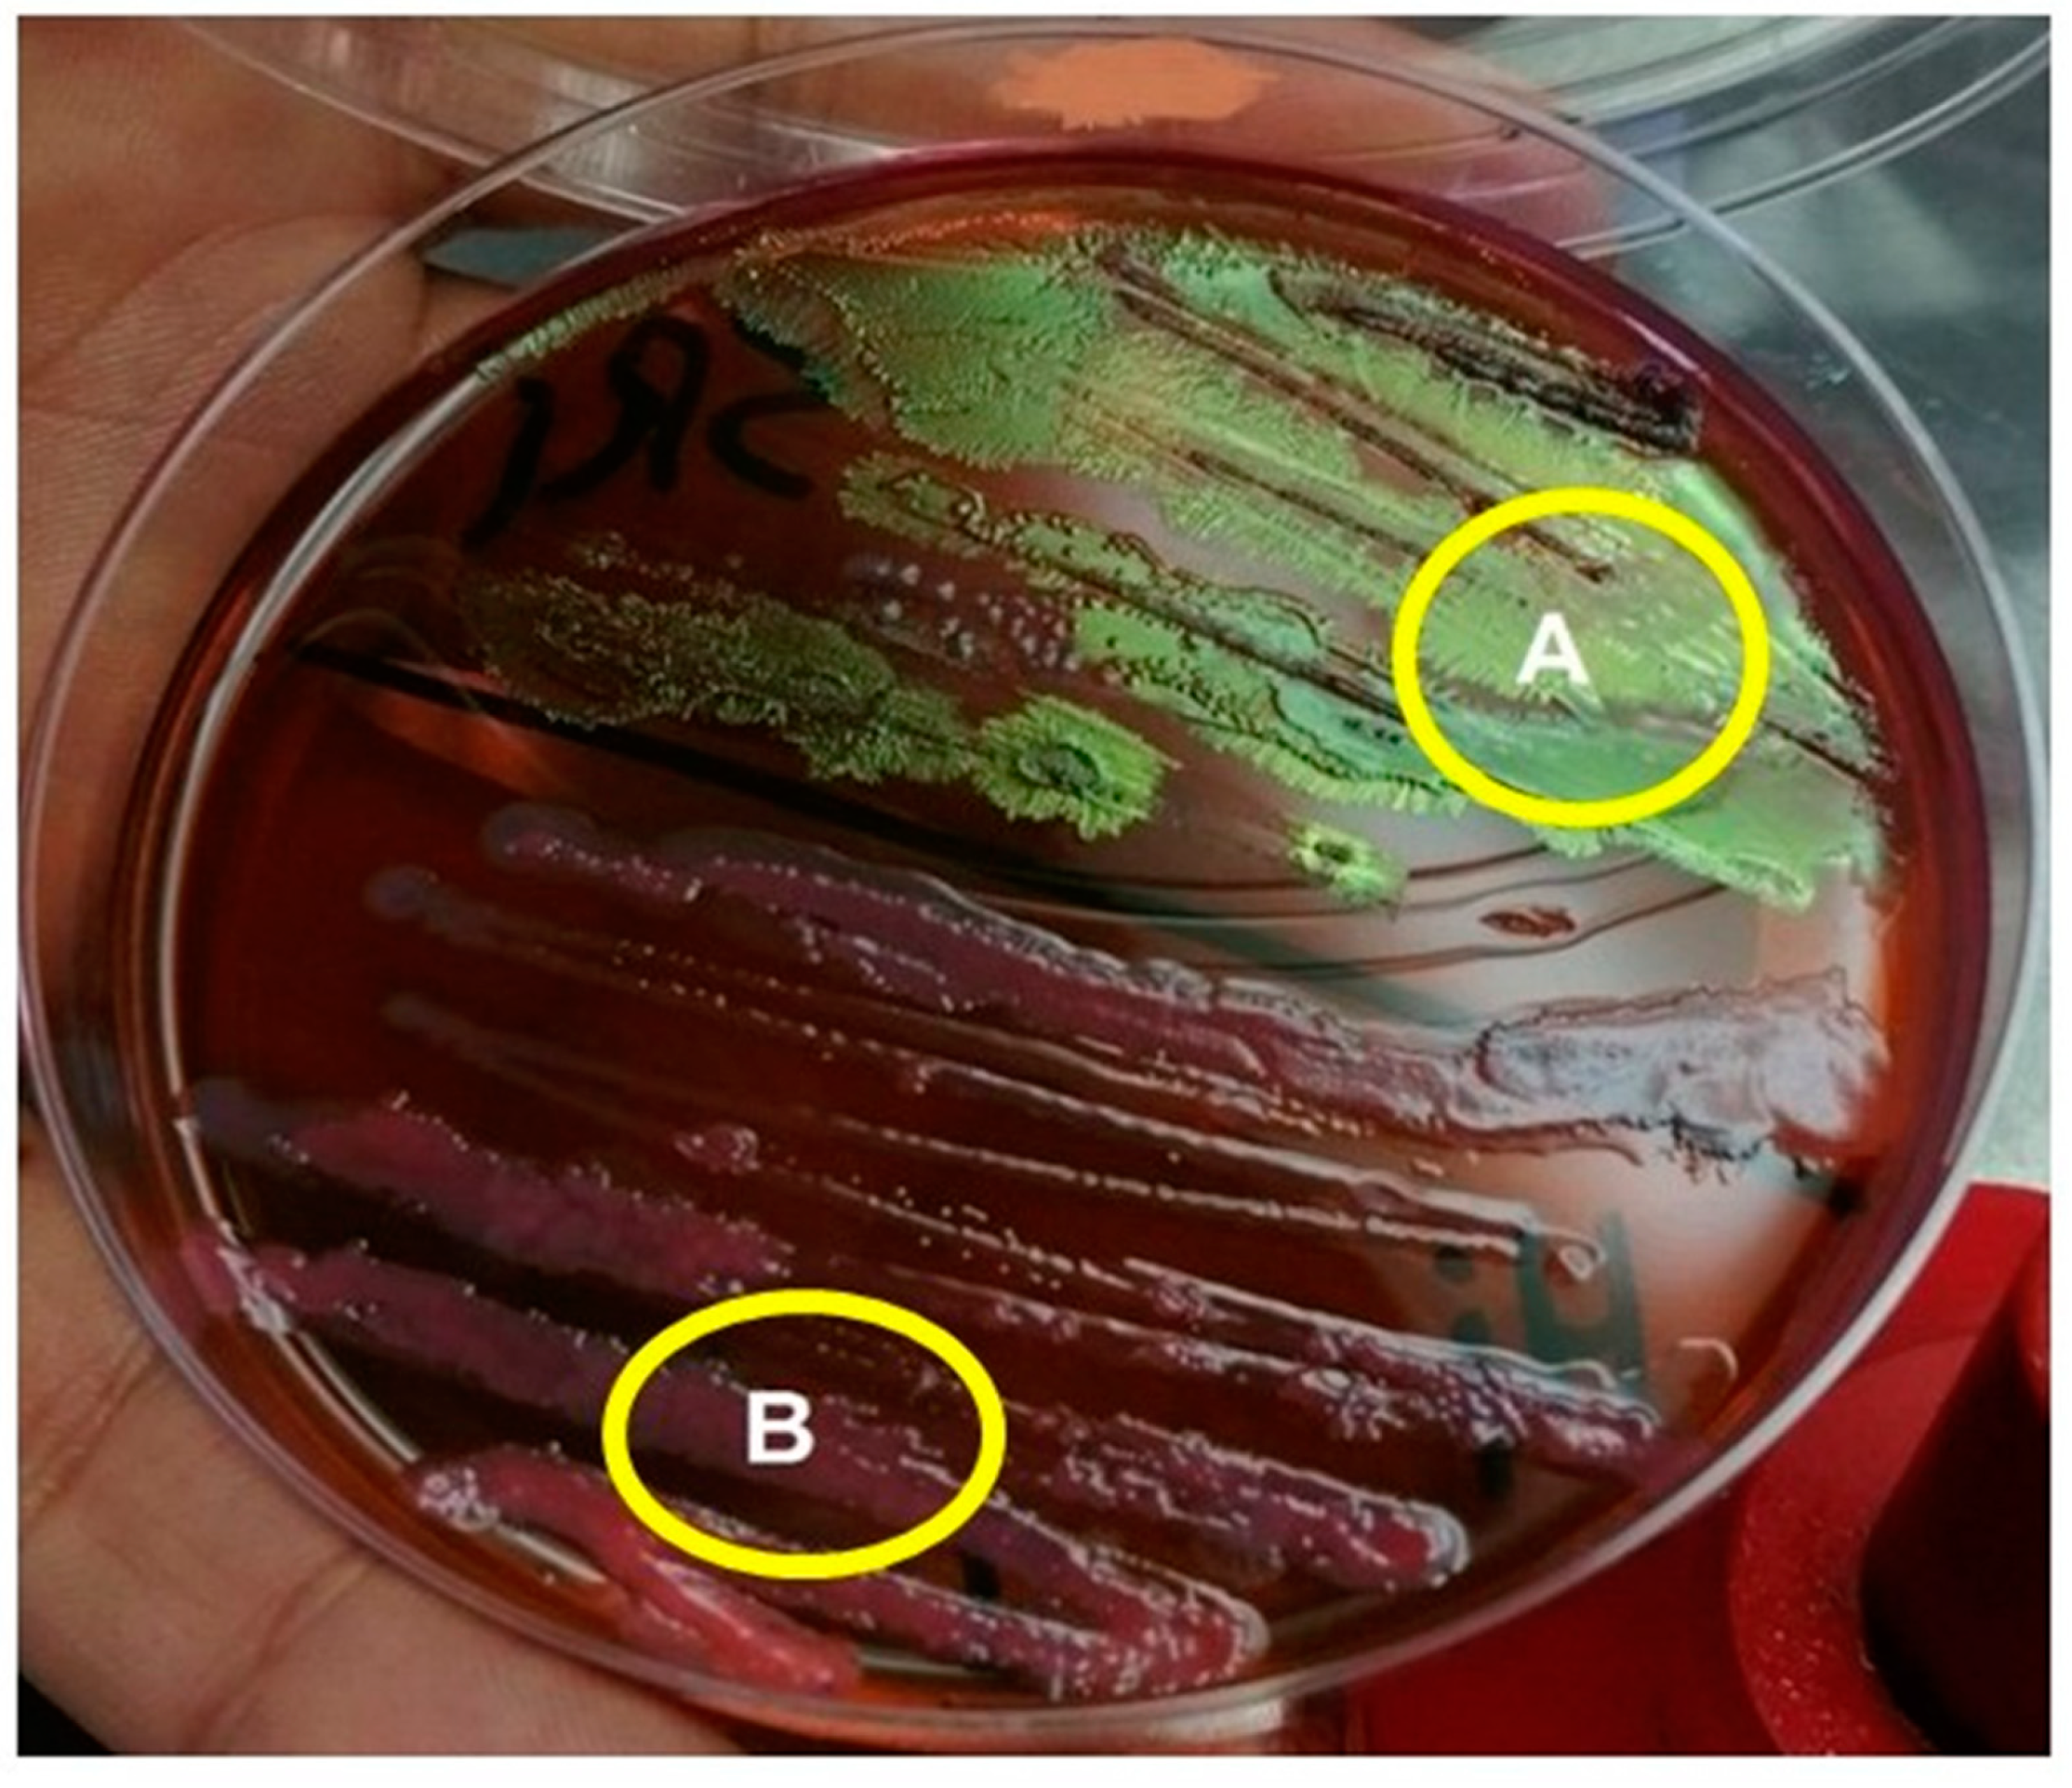
Biology 10 00999 g005

Can Symbiotic Bacteria (Xenorhabdus and Photorhabdus) Be More Efficient than Their Entomopathogenic Nematodes against Pieris rapae and Pentodon algerinus Larvae?
Abstract
:Simple Summary
Abstract
1. Introduction
2. Materials and Methods
2.1. Insects Used in the Current Investigation
2.2. Entomopathogenic Nematodes (EPNs)
2.3. Susceptibility of Third-Instar Larvae of P. rapae and P. algerinus to EPNs, S. riobravis, and H. bacteriophora
2.4. Isolation of the Symbiotic Bacteria, Photorhabdus sp. and Xenorhabdus sp.
2.5. Morphological Differentiation between the Two Types of Symbiotic Bacteria
2.6. Susceptibility of the Third-Instar Larvae of P. rapae and P. algerinus to Symbiotic Bacteria Xenorhabdus sp. and Photorhabdus sp.
2.7. Efficacy and Time-Course Viability of Symbiotic Bacteria (Xenorabdus sp. and Photorabdus sp.) against the Third-Instar Larvae of P. rapae under Field Conditions
2.8. Gas Chromatography–Mass Spectrophotometry (GC-MS) of Photorhabdus sp. and Xenorhabdus sp. Bacteria
2.9. Cytotoxicity of the Symbiotic Bacteria, Xenorhabdus sp. and Photorhabdus sp.
2.9.1. Cell Lines and Chemical Reagents
2.9.2. MTT Assay
2.10. Statistical Analysis
3. Results
3.1. Susceptibility of the Third-Instar Larvae of P. rapae to EPNs, H. bacteriphora and S. riobravis
3.2. Susceptibility of the Third-Instar Larvae of P. algerinus to EPNs, H. bacteriophora and S. riobravis
3.3. Lethal Concentration Values of EPNs, H. bacteriophora and S. riobravis, on the Third-Instar Larvae of P. rapae
3.4. Lethal Concentration Values of EPNs, H. bacteriophora and S. riobravis, on the Third-Instar Larvae of P. algerinus
3.5. Morphological Characterization of the Isolated Symbiotic Bacteria, Photorhabdus sp. and Xenorhabdus sp.
3.6. Efficacy of the Symbiotic Bacteria, Xenorhabdus sp. and Photorhabdus sp., against Pieris rapae Larvae
3.7. Efficacy of the Symbiotic Bacteria, Xenorhabdus sp. and Photorhabdus sp., against P. algerinus Larvae
3.8. Efficacy and Time-Course Viability of Entomopathogenic Bacteria, Xenorhabdus sp. and Photorhabdus sp. against the Third-Instar Larvae of P. rapae under Field Conditions
3.9. Gas Chromatography–Mass Spectrophotometry of Xenorhabdus sp. and Photorhabdus sp. Bacteria
3.9.1. Xenorhabdus sp. Bacterium
3.9.2. Photorhabdus sp. Bacterium
3.10. Morpho-Pathological Alterations in P. rapae and P. algerinus Larvae Caused by the Symbiotic Bacteria, Xenorhabdus sp. and Photorhabdus sp.
3.11. Cytotoxicity of the Isolated Symbiotic Bacteria, Xenorhabdus sp. and Photorhabdus sp.
4. Discussion
5. Conclusions
Author Contributions
Funding
Institutional Review Board Statement
Informed Consent Statement
Data Availability Statement
Conflicts of Interest
References
- Abd El-Salam, A.M.E. Field evaluation of some eco-friendly formulations against strawberry white grubs in Egypt. Spec. J. Biol. Sci. 2019, 5, 1–6. [Google Scholar]
- Abd-Rabou, S.; Saadia, A.A. New records of scarabaid white grub species and diptrean genus in sugar cane soil in upper Egypt (Coleoptera: Scarabidae). Egypt. J. Agric. Res. 2006, 84, 797–801. [Google Scholar]
- Aktar, W.; Sengupta, D.; Chowdhury, A. Impact of pesticides use in agriculture: Their benefits and hazards. Interdiscip. Toxicol. 2009, 2, 1–12. [Google Scholar] [CrossRef] [Green Version]
- Campos-Herrera, R.; Tailliez, P.; Pagès, S.; Ginibre, N.; Gutiérrez, C.; Boemare, N. Characterization of Xenorhabdus isolates from La Rioja (Northern Spain) and virulence with and without their symbiotic entomopathogenic nematodes (Nematoda: Steinernematidae). J. Invertebr. Pathol. 2009, 102, 173–181. [Google Scholar] [CrossRef] [PubMed]
- Pietri, J.E.; Liang, D. Virulence of entomopathogenic bacteria in the bed bug, Cimex lectularius. J. Invertebr. Pathol. 2018, 151, 1–6. [Google Scholar] [CrossRef] [PubMed]
- Stock, S.P. Partners in crime: Symbiont-assisted resource acquisition in Steinernema entomopathogenic nematodes. Curr. Opin. Insect Sci. 2019, 32, 22–27. [Google Scholar] [CrossRef]
- Sheetal, P.; Geetha, B.; Dandapani, V.; Devaraj, B. Mosquitocidal efficacy of lecithinase derived from entomopathogenic bacteria Xenorhabdus sp. strain PBU1755 against filarial vector Culex quinquefasciatus. Biocatal. Agric. Biotechnol. 2019, 17, 492–498. [Google Scholar] [CrossRef]
- Salvadori, J.D.M.; Defferrari, M.S.; Ligabue-Braun, R.; Lau, E.Y.; Salvadori, J.R.; Carlini, C.R. Characterization of ento-mopathogenic nematodes and symbiotic bacteria active against Spodoptera frugiperda (Lepidoptera: Noctuidae) and contribu-tion of bacterial urease to the insecticidal effect. Biol. Control. 2012, 63, 253–263. [Google Scholar] [CrossRef] [Green Version]
- Liu, J.; Berry, R.E.; Blouin, M.S. Identification of Symbiotic Bacteria (Photorhabdus and Xenorhabdus) from the Entomopathogenic Nematodes Heterorhabditis marelatus and Steinernema oregonense Based on 16S rDNA Sequence. J. Invertebr. Pathol. 2001, 77, 87–91. [Google Scholar] [CrossRef] [PubMed]
- Eleftherianos, I.; Joyce, S.A.; Ffrench-Constant, R.H.; Clarke, D.J.; Reynolds, S.E.; Ffrench-Constant, R. Probing the tritrophic interaction between insects, nematodes and Photorhabdus. Parasitology 2010, 137, 1695–1706. [Google Scholar] [CrossRef]
- Fang, X.; Li, Z.; Wang, Y.; Zhang, X. In vitro and in vivo antimicrobial activity of Xenorhabdus bovienii YL002 against Phytophthora capsici and Botrytis cinerea. J. Appl. Microbiol. 2011, 111, 145–154. [Google Scholar] [CrossRef]
- Shi, D.; An, R.; Zhang, W.; Zhang, G.; Yu, Z. Stilbene Derivatives from Photorhabdus temperata SN259 and Their Antifungal Activities against Phytopathogenic Fungi. J. Agric. Food Chem. 2017, 65, 60–65. [Google Scholar] [CrossRef]
- Bortoluzzi, L.; Alves, L.F.A.; Alves, V.S.; Holz, N. Entomopathogenic nematodes and their interaction with chemical insecticide aiming at the control of banana weevil borer, Cosmopolites sordidus Germar (Coleoptera: Curculionidae). Arq. Inst. Biol. 2013, 80, 183–192. [Google Scholar] [CrossRef] [Green Version]
- Abdolmaleki, A.H.R.; Maafi, Z.t.; Naseri, B. Virulence of two entomopathogenic nematodes through their interaction with Beauveria bassiana and Bacillus thuringiensis against Pieris brassicae (Lepidoptera: Pieridae). J. Crop. Prot. 2017, 6, 287–299. [Google Scholar]
- Gorgadze, O.; Bakhtadze, G.; Nebieridze, D. Efficacy of local entomopathogenic nematodes against Pieris brassicae (L, 1758) (Lepidoptera: Pieridae). Int. J. Dev. Res. 2018, 8, 23900–23903. [Google Scholar]
- Reda, E.S.; Sallam, A.M.; Ibrahim, H.Y.E.; Eid, S.M.E. Efficacy of Entomopathogenic Nematode, Steinernema carpocapsae and its Interaction with Beauveria bassiana against Pieris rapae L. (Lepidoptera: Pieridae). J. Plant Prot. Pathol. 2018, 9, 795–798. [Google Scholar] [CrossRef] [Green Version]
- Hinchliffe, S.J. Insecticidal Toxins from the Photorhabdus and Xenorhabdus Bacteria. Open Toxinol. J. 2010, 3, 83–100. [Google Scholar] [CrossRef]
- Vitta, A.; Thimpoo, P.; Meesil, W.; Yimthin, T.; Fukruksa, C.; Polseela, R.; Mangkit, B.; Tandhavanant, S.; Thanwisai, A. Larvicidal activity of Xenorhabdus and Photorhabdus bacteria against Aedes aegypti and Aedes albopictus. Asian Pac. J. Trop. Biomed. 2018, 8, 31. [Google Scholar] [CrossRef]
- Da Silva, W.J.; Júnior, H.L.P.; Heermann, R.; Da Silva, O.S. The great potential of entomopathogenic bacteria Xenorhabdus and Photorhabdus for mosquito control: A review. Parasites Vectors 2020, 13, 1–14. [Google Scholar] [CrossRef]
- Webb, S.; Shelton, A. Laboratory Rearing of the Imported Cabbage Worm. N. Y. Food Life Sci. Bull. 1988, 122. [Google Scholar]
- Kotchofa, R.; Baimey, H. In vivo production of entomopathogenic nematodes using Galleria mellonella: Costs and effect of diets on nematode pathogenicity. J. Nematol. 2019, 51, 1–15. [Google Scholar] [CrossRef] [PubMed] [Green Version]
- White, G.F. A method for obtaining infective nematode larvae from cultures. Science 1927, 66, 302–303. [Google Scholar] [CrossRef]
- Yuksel, E.; Taskesen, Y.E.; Erarslan, D.; Canhilal, R. Effectiveness of different entomopathogenic nematode species against the variegated cutworm, Peridroma saucia (Hubner) (Lepidoptera: Noctuidae). Egypt. J. Biol. Pest Control. 2018, 28. [Google Scholar] [CrossRef] [Green Version]
- Finney, D.J. Probit Analysis, 3rd ed.; Cambridge University Press: London, UK, 1971. [Google Scholar]
- Poinar, G.G.; Thomas, G.M. Significance of Achromobacter nematophilus Poinar and Thomas (Achromobacteraceae: Eubacteriales) in the development of the nematode, DD-136 (Neoaplectana sp., Steinernematidae). Parasitology 1966, 56, 385–390. [Google Scholar] [CrossRef]
- Yooyangket, T.; Muangpat, P.; Polseela, R.; Tandhavanant, S.; Thanwisai, A.; Vitta, A. Identification of entomopathogenic nematodes and symbiotic bacteria from Nam Nao National Park in Thailand and larvicidal activity of symbiotic bacteria against Aedes aegypti and Aedes albopictus. PLoS ONE 2018, 13, e0195681. [Google Scholar] [CrossRef] [PubMed]
- Fukruksa, C.; Yimthin, T.; Suwannaroj, M.; Muangpat, P.; Tandhavanant, S.; Thanwisai, A.; Vitta, A. Isolation and identification of Xenorhabdus and Photorhabdus bacteria associated with entomopathogenic nematodes and their larvicidal activity against Aedes aegypti. Parasites Vectors 2017, 10, 440. [Google Scholar] [CrossRef] [Green Version]
- Adithya, S.; Shivaprakash, M.; Sowmya, E. Evaluation of insecticidal activity of entomopathogenic bacteria Photorhabdus and Xenorhabdus against shoot and fruit borer Earias vittella (Lepidoptera: Noctuidae) of vegetable crops. J. Èntomol. Zoöl. Stud. 2020, 8, 2343–2348. [Google Scholar] [CrossRef]
- Minitab, Inc. Minitab Statistical Software, Release 14 for Windows; Minitab, Inc.: State College, PA, USA, 2003. [Google Scholar]
- Ali, S.S.; Pervez, R.; Hussain, M.A.; Ahmad, R. Susceptibility of three lepidopteran pests to five entomopathogenic nematodes and in vivo mass production of these nematodes. Arch. Phytopathol. Plant Prot. 2008, 41, 300–304. [Google Scholar] [CrossRef]
- Askary, T.H.; Ahmad, M.J. Efficacy of entomopathogenic nematodes against the cabbage butterfly (Pieris brassicae (L.) (Lepidoptera: Pieridae) infesting cabbage under field conditions. Egypt. J. Biol. Pest Control. 2020, 30, 1–7. [Google Scholar] [CrossRef]
- Grewal, P.; Power, K.; Grewal, S.; Suggars, A.; Haupricht, S. Enhanced consistency in biological control of white grubs (Coleoptera: Scarabaeidae) with new strains of entomopathogenic nematodes. Biol. Control. 2004, 30, 73–82. [Google Scholar] [CrossRef]
- Klein, M.G.; Grewal, P.S.; Jackson, T.A.; Koppenhöfer, A.M. Lawn, turf and grassland pests. In Field Manual of Techniques in Invertebrate Pathology: Application and Evaluation of Pathogens for Control of Insects and Other Invertebrate Pests, 2nd ed.; Lacey, L.A., Kaya, H.K., Eds.; Springer: Dordrecht, The Netherlands, 2007; pp. 655–675. [Google Scholar]
- Wu, S. Efficacy of Entomopathogenic Nematodes and Entomopathogenic Fungi against Masked Chafer White Grubs, Cyclocephala spp.(Coleoptera: Scarabaeidae). PhD Thesis, Virginia Tech, Blacksburg, VA, USA, 2013. [Google Scholar]
- Kajuga, J.; Hategekimana, A.; Yan, X.; Waweru, B.; Li, H.; Li, K.; Yin, J.; Cao, L.; Karanja, D.; Umulisa, C.; et al. Management of white grubs (Coleoptera: Scarabeidae) with entomopathogenic nematodes in Rwanda. Egypt. J. Biol. Pest Control. 2018, 28, 1–13. [Google Scholar] [CrossRef] [Green Version]
- Patil, J.; Rangasamy, V. Field evaluation of the entomopathogenic nematodes against the white grub, Leucopholis lepidophora Blanchard (Coleoptera: Scarabaeidae). Egypt. J. Biol. Pest Control. 2018, 28, 28–41. [Google Scholar] [CrossRef]
- Shapiro-Ilan, D.; Stuart, R.; McCoy, C.W. A Comparison of Entomopathogenic Nematode Longevity in Soil under Laboratory Conditions. J. Nematol. 2006, 38, 119–129. [Google Scholar]
- Shapiro-Ilan, D.I.; Gouge, D.H.; Piggott, S.J.; Fife, J.P. Application technology and environmental considerations for use of entomopathogenic nematodes in biological control. J. Biol. Control. 2006, 38, 124–133. [Google Scholar] [CrossRef]
- Bal, H.K.; Grewal, P.S. Lateral Dispersal and Foraging Behavior of Entomopathogenic Nematodes in the Absence and Presence of Mobile and Non-Mobile Hosts. PLoS ONE 2015, 10, e0129887. [Google Scholar] [CrossRef] [PubMed]
- Grewal, P.S.; Lewis, E.E.; Gaugler, R.; Campbell, J.F. Host finding behaviour as a predictor of foraging strategy in ento-mopathogenic nematodes. Parasitology 1994, 108, 207–215. [Google Scholar] [CrossRef]
- Dillon, A.B.; Ward, D.; Downes, M.J.; Griffin, C.T. Suppression of the large pine weevil Hylobius abietis (L.) (Coleoptera: Curculionidae) in pine stumps by entomopathogenic nematodes with different foraging strategies. Biol. Control. 2006, 38, 217–226. [Google Scholar] [CrossRef] [Green Version]
- Dillon, A.B.; Downes, M.J.; Ward, D.; Griffin, C.T. Optimizing application of entomopathogenic nematodes to manage large pine weevil, Hylobius abietis L. (Coleoptera:Curculionidae) populations developing in pine stumps, Pinus sylvestris. Biol. Control. 2007, 40, 253–263. [Google Scholar] [CrossRef] [Green Version]
- Bedding, R.A.; Molynou, A.S.; Åkhurst, R.J. Heterorhabditis spp., Neoaplectana spp. and Steinernema kraussei: Interspecific and intraspecific differences in infectivity for insects. Exp. Parasitol. 1983, 55, 249–257. [Google Scholar] [CrossRef]
- Gouge, D.H.; Lee, L.L.; Henneberry, T.J. Effect of temperature and lepidopteran host species on entomopathogenic nematode (Nematoda: Steinernemtidae, Heterorhabditidae) infection. Environ. Entomol. 1999, 28, 876–883. [Google Scholar] [CrossRef]
- Menti, H.; Wright, D.J.; Perry, R.N. Infectivity of populations of entomopathogenic nematodes Steinernema feltiae and Het-erorhabditis megidis in relation to temperature, age and lipid content. Nematology 2000, 2, 515–521. [Google Scholar] [CrossRef]
- Silva, C.P.; Waterfield, N.R.; Daborn, P.J.; Dean, P.; Chilver, T.; Au, C.P.Y.; Sharma, S.; Potter, U.; Reynolds, S.E.; Ffrench-Constant, R.H. Bacterial infection of a model insect: Photorhabdus luminescens and Manduca sexta. Cell. Microbiol. 2002, 4, 329–339. [Google Scholar] [CrossRef] [Green Version]
- Medeiros, J.; Rosa, J.S.; Tavares, J.; Simões, N. Susceptibility of Pseudaletia unipuncta (Lepidoptera: Noctuidae) to ento-mopathogenic nematodes (Rhabditida: Steinernematidae and Heterorhabditidae) isolated in the Azores: Effect of nematode strain and host age. J. Econ. Entomol. 2000, 93, 1403–1408. [Google Scholar] [CrossRef]
- Lewis, E.E.; Gaugler, R.; Harrison, R. Response of cruiser and ambusher entomopathogenic nematodes (Steinernematidae) to host volatile cues. Can. J. Zoöl. 1993, 71, 765–769. [Google Scholar] [CrossRef]
- Boff, M.I.C.; Wiegers, G.I.; Smits, P.H. Influences of host size and host species on the infectivity and development of Het-erorhabditis megidis (strain NLH-E87.3). BioControl 2000, 45, 469–482. [Google Scholar] [CrossRef]
- Mahar, A. Studies of Different Application Methods of Xenorhabdus and Photorhabdus Cells and Their Toxin in Broth Solution to Control Locust (Schistocerca gregaria). Asian J. Plant Sci. 2004, 3, 690–695. [Google Scholar] [CrossRef]
- Rahoo, A.M.; Mukhtar, T.; Gowen, S.R.; Pembroke, B. Virulence of entomopathogenic bacteria Xenorhabdus bovienii and Photorhabdus luminescens against Galleria mellonella larvae. Pak. J. Zool. 2011, 43, 543–548. [Google Scholar]
- Da Silva, O.S.; Prado, G.R.; Da Silva, J.L.R.; Silva, C.E.; Da Costa, M.; Heermann, R. Oral toxicity of Photorhabdus lumi-nescens and Xenorhabdus nematophila (Enterobacteriaceae) against Aedes aegypti (Diptera: Culicidae). Parasitol Res. 2013, 112, 2891–2896. [Google Scholar] [CrossRef] [PubMed]
- Kim, I.-H.; Aryal, S.K.; Aghai, D.T.; Casanova-Torres, Á.M.; Hillman, K.; Kozuch, M.P.; Mans, E.J.; Mauer, T.J.; Ogier, J.-C.; Ensign, J.C.; et al. The insect pathogenic bacterium Xenorhabdus innexi has attenuated virulence in multiple insect model hosts yet encodes a potent mosquitocidal toxin. BMC Genom. 2017, 18, 927. [Google Scholar] [CrossRef] [Green Version]
- Forst, S.; Dowds, B.; Boemare, N.; Stackebrandt, E. Xenorhabdus and Photorhabdus spp.: Bugs that kill bugs. Annu. Rev. Microbiol. 1997, 51, 47–72. [Google Scholar] [CrossRef] [PubMed]
- Ffrench-Constant, R.H.; Bowen, D.J. Novel insecticidal toxins from nematode symbiotic bacteria. Cell. Mol. Life Sci. 2000, 57, 828–833. [Google Scholar] [CrossRef]
- Ffrench-Constant, R.H.; Dowling, A.; Waterfield, N. Insecticidal toxins from Photorhabdus bacteria and their potential use in agriculture. Toxicon 2007, 49, 436–451. [Google Scholar] [CrossRef]
- Dillman, A.R.; Guillermin, M.L.; Lee, J.H.; Kim, B.; Sternberg, P.W.; Hallem, E.A. Olfaction shapes host-parasite interactions in parasitic nematodes. Proc. Natl. Acad. Sci. USA 2012, 109, E2324–E2333. [Google Scholar] [CrossRef] [PubMed] [Green Version]
- Daborn, P.J.; Waterfield, N.; Silva, C.P.; Au, C.P.Y.; Sharma, S.; Ffrench-Constant, R.H. A single Photorhabdus gene, makes caterpillars floppy (mcf), allows Escherichia coli to persist within and kill insects. Proc. Natl. Acad. Sci. USA 2002, 99, 10742–10747. [Google Scholar] [CrossRef] [Green Version]
- Dowling, A.J.; Daborn, P.J.; Waterfield, N.R.; Wang, P.; Streuli, C.H.; Ffrench-Constant, R.H. The insecticidal toxin Makes caterpillars floppy (Mcf) promotes apoptosis in mammalian cells. Cell. Microbiol. 2004, 6, 345–353. [Google Scholar] [CrossRef] [PubMed]
- Dowling, A.J.; Waterfield, N.R.; Hares, M.C.; Le Goff, G.; Streuli, C.H.; Ffrench-Constant, R.H. The Mcf1 toxin induces apoptosis via the mitochondrial pathway and apoptosis is attenuated by mutation of the BH3-like domain. Cell. Microbiol. 2007, 9, 2470–2484. [Google Scholar] [CrossRef] [PubMed]
- Vivekanandhan, P.; Kavitha, T.; Karthi, S.; Senthil-Nathan, S.; Shivakumar, M.S. Toxicity of Beauveria bassiana-28 Mycelial Extracts on Larvae of Culex quinquefasciatus Mosquito (Diptera: Culicidae). Int. J. Environ. Res. Public Health 2018, 15, 440. [Google Scholar] [CrossRef] [Green Version]
- Ullah, I.; Khan, A.L.; Ali, L.; Khan, A.R.; Waqas, M.; Lee, I.J.; Shin, J.H. An insecticidal compound produced by an in-sect-pathogenic bacterium suppresses host defenses through phenoloxidase inhibition. Molecules 2014, 19, 20913–20928. [Google Scholar] [CrossRef] [Green Version]
- Ullah, I.; Khan, A.L.; Ali, L.; Khan, A.R.; Waqas, M.; Hussain, J.; Lee, I.-J.; Shin, J.-H. Benzaldehyde as an insecticidal, antimicrobial, and antioxidant compound produced by Photorhabdus temperata M1021. J. Microbiol. 2015, 53, 127–133. [Google Scholar] [CrossRef]
- Hasana, A.; Ahmeda, S.; Mollaha, M.M.I.; Leeb, D.; Kima, Y. Variation in pathogenicity of different strains of Xenorhabdus nematophila; Differential immunosuppressive activities and secondary metabolite production. J. Invertebr. Pathol. 2019, 166, 107221. [Google Scholar] [CrossRef]
- Mollah, M.I.; Kim, Y. Virulent secondary metabolites of entomopathogenic bacteria genera, Xenorhabdus and Photorhabdus, inhibit phospholipase A2 to suppress host insect immunity. BMC Microbiol. 2020, 20, 359. [Google Scholar] [CrossRef]
- Hemalatha, D.; Prabhu, S.; Rani, W.B.; Anandham, R. Isolation and characterization of toxins from Xenorhabdus nematophilus against Ferrisia virgata (Ckll.) on tuberose, Polianthes tuberosa. Toxicon 2018, 146, 42–49. [Google Scholar] [CrossRef]
- Burke, J.E.; Dennis, E.A. Phospholipase A2 structure/function, mechanism, and signaling. J. Lipid Res. 2009, 50, S237–S242. [Google Scholar] [CrossRef] [PubMed] [Green Version]
- Seo, S.; Lee, S.; Hong, Y.; Kim, Y. Phospholipase A 2 Inhibitors Synthesized by Two Entomopathogenic Bacteria, Xenorhabdus nematophila and Photorhabdus temperata subsp. temperata. Appl. Environ. Microbiol. 2012, 78, 3816–3823. [Google Scholar] [CrossRef] [PubMed] [Green Version]
- Wright, R.J.; Villani, M.G.; Agudelo-Silva, F. Steinernematid and Heterorhabditid Nematodes for Control of Larval European Chafers and Japanese Beetles (Coleoptera: Scarabaeidae) in Potted Yew. J. Econ. Èntomol. 1988, 81, 152–157. [Google Scholar] [CrossRef]
- Shanks, C.H., Jr.; Fernando, A. Field Pathogenicity and Persistence of Heterorhabditid and Steinernematid Nematodes (Nematoda) Infecting Black Vine Weevil Larvae (Coleoptera: Curculionidae) in Cranberry Bogs. J. Econ. Entomol. 1990, 83, 107–110. [Google Scholar] [CrossRef]
- Klein, M.G.; Georgis, R. Persistence of Control of Japanese Beetle (Coleoptera: Scarabaeidae) Larvae with Steinernematid and Heterorhabditid Nematodes. J. Econ. Èntomol. 1992, 85, 727–730. [Google Scholar] [CrossRef]
- Shields, E.J.; Testa, A.; Miller, J.M.; Flanders, K.L. Field Efficacy and Persistence of the Entomopathogenic Nematodes Heterorhabditis bacteriophora ‘Oswego’ and H. bacteriophora ‘NC’ on Alfalfa Snout Beetle Larvae (Coleoptera: Curculionidae). Environ. Entomol. 1999, 28, 128–136. [Google Scholar] [CrossRef]
- Susurluk, A.; Ehlers, R.-U. Field persistence of the entomopathogenic nematode Heterorhabditis bacteriophora in different crops. BioControl 2008, 53, 627–641. [Google Scholar] [CrossRef]
- Ferguson, C.S.; Schroeder, P.C.; Shields, E.J. Vertical Distribution, Persistence, and Activity of Entomopathogenic Nematodes (Nematoda: Heterorhabditidae and Steinernematidae) in Alfalfa Snout Beetle-(Coleoptera: Curculionidae) Infested Fields. Environ. Èntomol. 1995, 24, 149–158. [Google Scholar] [CrossRef] [Green Version]
- Wright, R.J.; Agudelo-Silva, F.; Georgis, R. Soil Applications of Steinernematid and Heterorhabditid Nematodes for Control of Colorado Potato Beetles, Leptinotarsa decemlineata (Say). J. Nematol. 1987, 19, 201–206. [Google Scholar] [PubMed]
- Sikora, R.A.; Coyne, D.; Hallmann, J.; Timper, P. (Eds.) Plant parasitic nematodes in subtropical and tropical agriculture; CABI: Cambridge, UK, 2018. [Google Scholar]
- Gerritsen, L.J.; Georgieva, J.; Wiegers, G.L. Oral toxicity of Photorhabdus toxins against thrips species. J. Invertebr. Pathol. 2005, 88, 207–211. [Google Scholar] [CrossRef] [PubMed]

| EPNs | Exposure Period (h) | LC50 (95%FL) | LC90 (95%FL) | Slope |
|---|---|---|---|---|
| Heterorhabditis bacteriophora | 24 | 56.88 (26.26–123.25) | 1178.41 (543.86–2553.30) | 0.90 |
| 48 | 35.52 (15.43–81.75) | 948.28 (412.03–2182.44) | 0.97 | |
| 72 | 32.19 (15.11–68.57) | 647.84 (304.18–1379.76) | 1.01 | |
| Steinernema riobravis | 24 | 125.39 (50.63–310.56) | 4325.11 (1746.38–10711.65) | 0.83 |
| 48 | 50.15 (20.96–119.98) | 1580.56 (660.61–3781.61) | 0.86 | |
| 72 | 35.14 (16.95–72.83) | 606.22 (292.51–1256.36) | 1.05 |
| EPNs | Exposure Period (h) | LC50 | LC90 | Slope |
|---|---|---|---|---|
| Heterorhabditis bacteriophora | 24 | 22.79 (10.89–47.68) | 365.36 (174.67–764.23) | 1.06 |
| 48 | 19.15 (9.37–39.12) | 264.28 (129.37–539.90) | 1.12 | |
| 72 | 19.00 (9.82–35.24) | 162.53 (90.09–293.22) | 1.43 | |
| Steinernema riobravis | 24 | 91.50 (41.93–199.68) | 1927.89 (883.43–4207.20) | 0.974 |
| 48 | 55.02 (27.37–110.61) | 829.61 (412.69–1667.74) | 1.09 | |
| 72 | 43.50 (22.59–83.77) | 547.12 (284.10–1053.61) | 1.17 |
| Peak No. | Rentation Time | Area% | Compound Name | Molecular Formula |
|---|---|---|---|---|
| 1 | 5.63 | 2.11 | 7-NONENOIC-7,8-D2 ACID, METHYL ESTER | C10H16D2O2 |
| 2 | 5.84 | 2.63 | Paromomycin | C23H45N5O14 |
| 3 | 7.48 | 35.04 | 2-PYRROLIDINONE | C4H7NO |
| 4 | 8.87 | 4.53 | 2,2-DIDEUTERO OCTADECANAL | C18H34D2O |
| 5 | 12.81 | 2.62 | 1-TETRADECANOL | C14H30O |
| 6 | 13.19 | 2.37 | 2,8,9-Trioxa-5-aza-1-silabicyclo[3 .3. 3]undecane, 1-methyl- | C7H15NO3Si |
| 7 | 15.66 | 4.92 | 1,4-benzenediol, 2-(1,1-dimethylethyl)-5-(2-propenyl)- | C13H18O2 |
| 8 | 16.89 | 3.19 | 4-Octadecenal | C18H34O |
| 9 | 22.92 | 2.87 | CYCLOPENTANETRIDECANOIC ACID, METHYL ESTER | C19H36O2 |
| 10 | 23.97 | 13.86 | 9-OCTADECENOIC ACID (Z)-(Oleic Acid) | C18H34O2 |
| 11 | 24.06 | 2.72 | hexadecanoic acid, 2,3-dihydroxypropyl ester | C19H38O4 |
| 12 | 27.06 | 3.42 | OCTADECANOIC ACID | C18H36O2 |
| 13 | 31.98 | 2.80 | 1,2-benzenedicarboxylic acid | C24H38O4 |
| 14 | 35.28 | 2.00 | Docosanoic acid, 1,2,3-propanetriyl ester | C69H134O6 |
| Peak Number | Rentation Time | Area% | Compound Name | Molecular Formula |
|---|---|---|---|---|
| 1 | 6.39 | 1.42 | ACETIC ACID, OCTYL ESTER | C10H20O2 |
| 2 | 7.51 | 44.09 | 2-Piperidinone | C5H9NO |
| 3 | 8.30 | 13.20 | 1,2-benzenedicarboxylic acid | C8H6O4 |
| 4 | 12.81 | 2.66 | 1-TETRADECANOL | C14H30O |
| 5 | 15.63 | 4.25 | 15-METHYLTRICYCLO[6.5.2(13,14).0(7,15)]PENTADECA-1,3,5,7,9,11,13-HEPTENE | C16H14 |
| 6 | 16.31 | 2.28 | 2(1H)-NAPHTHALENONE, OCTAHYDRO-1-METHYL-1-(2-P ROPENYL)-, (1à,4Aá,8Aà)- | C14H22O |
| 7 | 16.89 | 4.66 | 4-Trifluoroacetoxytetradecane | C16H29F3O2 |
| 8 | 20.30 | 5.57 | 1-EICOSANOL | C20H42O |
| 9 | 22.22 | 2.91 | Bacteriochlorophyll-c-stearyl | C52H72MgN4O4 |
| 10 | 22.93 | 14.43 | PENTADECANOIC ACID,14-METHYL-, METHYL ESTER | C17H34O2 |
| 11 | 26.10 | 3.92 | OCTADECANOIC ACID, METHYL ESTER | C19H38O2 |
| 12 | 27.06 | 2.26 | Erucic acid | C22H42O2 |
| Treatments | Percentage Viability of WI-38 Human Cells (%) |
|---|---|
| Xenorhabdus sp. | 85.33 ± 1.52 |
| Photorhabdus sp. | 81.66 ± 3.05 |
| Control (samples treated only with medium) | 88.00 ± 4.00 |
Publisher’s Note: MDPI stays neutral with regard to jurisdictional claims in published maps and institutional affiliations. |
© 2021 by the authors. Licensee MDPI, Basel, Switzerland. This article is an open access article distributed under the terms and conditions of the Creative Commons Attribution (CC BY) license (https://creativecommons.org/licenses/by/4.0/).
Share and Cite
Elbrense, H.; Elmasry, A.M.A.; Seleiman, M.F.; AL-Harbi, M.S.; Abd El-Raheem, A.M. Can Symbiotic Bacteria (Xenorhabdus and Photorhabdus) Be More Efficient than Their Entomopathogenic Nematodes against Pieris rapae and Pentodon algerinus Larvae? Biology 2021, 10, 999. https://doi.org/10.3390/biology10100999
Elbrense H, Elmasry AMA, Seleiman MF, AL-Harbi MS, Abd El-Raheem AM. Can Symbiotic Bacteria (Xenorhabdus and Photorhabdus) Be More Efficient than Their Entomopathogenic Nematodes against Pieris rapae and Pentodon algerinus Larvae? Biology. 2021; 10(10):999. https://doi.org/10.3390/biology10100999
Chicago/Turabian StyleElbrense, Hanaa, Amr M. A. Elmasry, Mahmoud F. Seleiman, Mohammad S. AL-Harbi, and Ahmed M. Abd El-Raheem. 2021. "Can Symbiotic Bacteria (Xenorhabdus and Photorhabdus) Be More Efficient than Their Entomopathogenic Nematodes against Pieris rapae and Pentodon algerinus Larvae?" Biology 10, no. 10: 999. https://doi.org/10.3390/biology10100999
APA StyleElbrense, H., Elmasry, A. M. A., Seleiman, M. F., AL-Harbi, M. S., & Abd El-Raheem, A. M. (2021). Can Symbiotic Bacteria (Xenorhabdus and Photorhabdus) Be More Efficient than Their Entomopathogenic Nematodes against Pieris rapae and Pentodon algerinus Larvae? Biology, 10(10), 999. https://doi.org/10.3390/biology10100999








